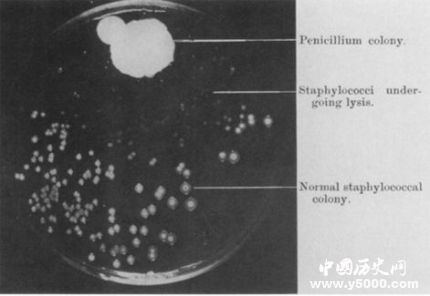

胶鬲是谁
2023-11-17 21:59:53
弗莱明是怎么发现青霉素的:其实都是巧合
亚历山大·弗莱明(Alexander Fleming,1881年8月6日—1955年3月11日),英国细菌学家,生物化学家,微生物学家。

亚历山大·弗莱明于1923年发现溶菌酶,1928年首先发现了青霉素。后英国病理学家弗劳雷、德国生物化学家钱恩进一步研究改进,并成功的用于医治人的疾病,三人共获诺贝尔生理或医学奖。
青霉素的发现,使人类找到了一种具有强大杀菌作用的药物,结束了传染病几乎无法治疗的时代;从此出现了寻找抗菌素新药的高潮,人类进入了合成新药的新时代。
在美国学者麦克·哈特所著的《影响人类历史进程的100名人排行榜》,弗莱明名列第45位。
弗莱明是怎么发现青霉素的
第一次世界大战期间,英国皇家陆军医疗队队长亚历山大·弗莱明在法国呆了一段时间。他发现,法国佛兰德斯战场产生的伤口都比较污秽,那些泥泞随着高速运行的武器一起切入到士兵的身体内,会使创伤的后果更加严重。
那时候没有抗生素,只能用消毒水处理伤口,然而用大量消毒剂使劲冲刷伤口起到的副作用也不容忽视——消毒水杀死了伤口处的细菌,同时也杀死了人体自身的正常细胞。
人们都希望能够找出一种能够特异性地杀死细菌的药剂,但这是一个人类未知的领域,谁也不知道谁将有幸成为新世界的开门人。一战后,弗莱明回到伦敦工作,开始专心致志地研究感染伤口最常见的病菌葡萄球菌,并试图找出杀死它们的方法。
1928年9月,弗莱明结束了度假归来——在度假之前,他把所有细菌培养基一股脑堆在了实验室角落的长椅上。结果,他发现其中一个培养基不慎被霉菌污染了,霉菌周围一圈的葡萄球菌都被杀死了。当时的卫生条件不怎么样,培养基被污染这种情况其实很常见,大部分的研究员都会把异常的培养基丢掉,只有弗莱明下了一句很著名的评论:“这很有趣啊。”

弗莱明认为,霉菌分泌了一些可以杀死葡萄球菌的物质。于是他趁热打铁,小心翼翼地提取了培养基里的霉菌,将它们纯化培养起来,发现这些霉菌其实就是青霉菌(又名盘尼西林),它们的分泌物可以杀死导致人类生病的某些葡萄球菌。
霉菌能够杀菌并不是稀罕事,这早在半个世纪以前,就被约翰·廷德尔描述过。1876年,在观察一块羊肉的腐烂过程时,廷德尔注意到上面生长的细菌能够被霉菌所杀死。廷德尔记录下了这种霉菌的名字——盘尼西林,并这样纪录道:“在霉菌厚且连贯的地方,细菌都死掉了,亦或是进入了休眠状态。”
19世纪的其他一些科学家们,包括巴斯德、利斯特等人,都试图利用青霉菌来治疗感染的伤口,但由于操作难度太大,最后都放弃了。
弗莱明决定从这里入手,找出青霉菌杀死葡萄球菌的秘密。他试着提纯这种杀菌物质(1929年,他将这种未知的物质命名为青霉素),但是没有成功:成品里含有太多的杂质,弗莱明非常清楚这种混合物绝对不能被草率地注射到人体内。屡战屡败的弗莱明最终放弃了青霉素的治疗价值。
1929年,他发表了一篇名为《关于青霉菌的抗菌行为——特别参考它们在分离流行性感冒B病菌中的应用》的医学论文,作为他对于青霉菌研究的终结。
在这篇文章里,他完全抛弃了要将青霉素作为药剂使用的主意,主要讲述了利用青霉菌分离流行性感冒B病菌的方法:因为青霉素可以杀死很多细菌,但不能伤害流行性感冒B病菌,所以只要在培养皿里滴入青霉菌,那么就可以得到纯化的流行性感冒B病菌,这对于研究流行性感冒B病菌的微生物学家来说可是个好消息。
放弃了青霉素的弗莱明转向了对其他东西的研究。但是,出于微弱的希望,他依然在培养皿里培育着青霉菌,并偶尔谈及青霉素,坚信它可能会是人类的宝贵财富。
2023-11-17 21:59:53
2023-11-17 21:57:38
2023-11-17 21:55:23
2023-11-17 21:53:08
2023-11-17 21:50:53
2023-11-17 21:48:39
2023-11-17 21:46:24
2023-11-17 21:44:09
2023-11-17 21:41:54
2023-11-17 18:28:12
2023-11-17 18:25:58
2023-11-17 18:23:43
2023-11-17 18:21:28
2023-11-17 18:19:14
2023-11-17 18:16:58
2023-11-17 18:14:44
2023-11-17 18:12:29
2023-11-17 18:10:14
2023-11-17 18:07:59
2023-11-17 14:54:13